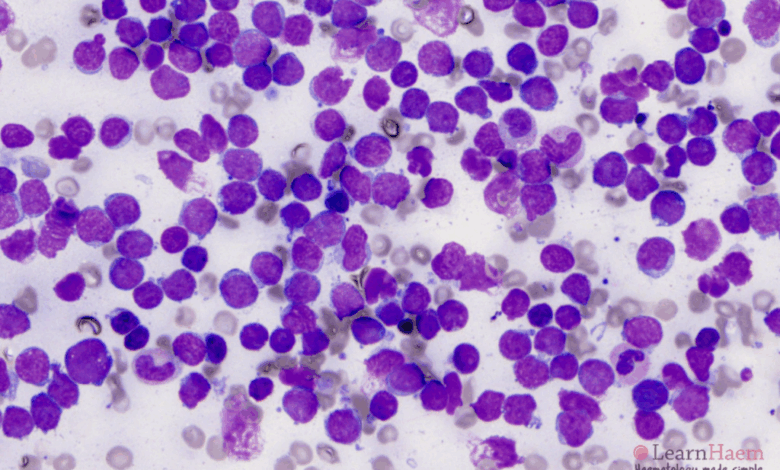

Joy Cancer Awareness Month: Why Acute Lymphoblastic Leukaemia is the most common childhood cancer

A Paediatric Oncologist at the Korle-Bu Teaching Hospital, Dr Samira Yamyolia, has shed light on why Acute Lymphoblastic Leukaemia (ALL) remains the most common form of childhood cancer in Ghana and around the world.
Speaking on the Joy FM Super Morning Show on Wednesday, October 29, as part of Joy Cancer Awareness Month, Dr Yamyolia explained that leukaemia refers to cancers that affect the blood.
“Leukaemias are cancers of the blood and, in children, it is the commonest type we see. It’s the same pattern worldwide, and Ghana is no different.”
She described ALL as a condition in which the body’s bone marrow produces an abnormally high number of immature white blood cells known as lymphoblasts.
“These white cells are not mature, and so they do not function as they should. They grow in very large quantities and begin to affect the production of other important blood components such as platelets and haemoglobin,” she explained.
Dr Yamyolia added that this process leaves the child with many abnormal white cells that do not work properly, and at the same time, a shortage of red blood cells and platelets.
According to her, leukaemia is not hereditary but occurs sporadically, meaning its exact cause is often unknown.
“Like most childhood cancers, the exact cause is not known,” she said.
Dr Yamyolia outlined how doctors diagnose the disease through blood tests and bone marrow examinations.
“We can start with a simple blood test called a full blood count and blood film, then confirm it with a bone marrow aspirate,” she said.
“The bone marrow is the factory of the blood, and looking at it under the microscope helps us identify the type of leukaemia.”
She said that early detection and diagnosis are critical for survival, adding that parents should report any unusual symptoms to a health facility promptly.
“There is help available. The good news is that ALL is curable, and children can recover completely with proper treatment,” she assured.
DISCLAIMER: The Views, Comments, Opinions, Contributions and Statements made by Readers and Contributors on this platform do not necessarily represent the views or policy of Multimedia Group Limited.
DISCLAIMER: The Views, Comments, Opinions, Contributions and Statements made by Readers and Contributors on this platform do not necessarily represent the views or policy of Multimedia Group Limited.
Source link




